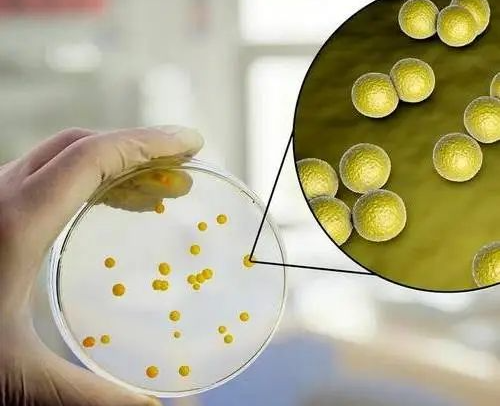

近期,根据国家、市级工作要求,各卫生监督所对辖区内公共场所开展了国家“双随机”监督检查工作。依据《公共场所卫生指标及限制要求》(GB 37488-2019)标准,公共用品用具和室内空气质量的检测指标有哪些?各位经营者有踩到这些红线吗?一起了解下:
公共用品用具指提供给顾客重复使用的床单、枕套、被套、毛巾、浴巾、浴衣、杯具、洁具、拖鞋、美容美发工具、修脚工具以及其他重复使用且与皮肤、黏膜等接触的物品。

(GB 37488-2019)

标准:表面清洁,无污渍,无异味等。
标准:6.5~8.5
人体皮肤pH值在5.5—7.0之间,棉纺织品pH值不合格,残留的化学品可与皮肤的酸性物质发生中和反应,破坏人体皮肤的平衡,引起人体过敏和皮炎、皮痒、红肿、湿疹等皮肤病,严重者可诱发感染等不适。
指样品经培养所生长发育的嗜中温性需氧和兼性厌氧菌落的总数。清洗消毒保洁工作不到位是细菌总数超标的主要原因。
在一定培养条件下能发酵乳糖,产酸产气的需氧和兼性厌氧革兰氏阴性无芽孢杆菌。
标准:在与检验方法相对应的采样面积内不得检出。

人类的一种重要病原菌,隶属葡萄球菌属,可引起许多严重感染。
标准要求:棉织品、美容美发工具、修脚工具不得检出金黄色葡萄球菌。
室内CO2浓度限值:有睡眠、休憩需求的公共场所≤0.10%;其他场所≤0.15%。
对有睡眠、休憩需求的公共场所,室内空气细菌总数不应大于1500CFU/m³或 20 CFU/m³;其他场所室内空气细菌总数不应大于4000CFU/m³或40CFU/m³。
注:根据细菌总数不同采样方法选取不同限值要求。
